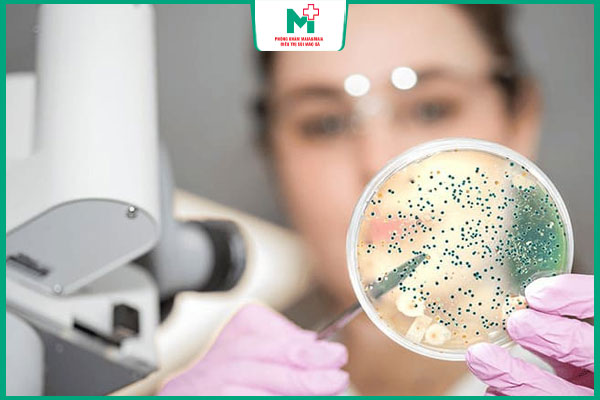
xét nghiệm nuôi cấy lậu cầu

Xét nghiệm bệnh lậu đóng vai trò thiết yếu trong việc chẩn đoán chính xác tình trạng nhiễm khuẩn, từ đó giúp người bệnh tiếp cận phác đồ điều trị kịp thời và hiệu quả, ngăn ngừa các biến chứng sức khỏe nghiêm trọng. Cùng tìm hiểu chi tiết qua bài viết sau của Phòng khám Maia&Maia.
I. Khi nào nên xét nghiệm bệnh lậu?
Phát hiện bệnh lậu sớm sẽ giúp gia tăng hiệu quả điều trị. Do đó, mọi người hãy chủ động đi xét nghiệm bệnh lậu trong các trường hợp sau:
- Có biểu hiện tiểu buốt, tiểu rát, tiết dịch bất thường ở dương vật hoặc âm đạo, đau khi quan hệ,…
- Bạn tình được chẩn đoán mắc bệnh lậu hoặc bệnh lây truyền qua đường tình dục khác.
- Từng quan hệ với người mắc bệnh lậu
- Đối tượng bị bệnh giang mai, sùi mào gà,…
- Người có mong muốn kiểm tra sức khỏe sinh sản định kỳ, đặc biệt trước khi kết hôn hoặc sinh con
- Phụ nữ mang thai có nguy cơ lây nhiễm bệnh từ bạn tình
- Đối tượng sử dụng chung đồ dùng cá nhân hay dịch tiết từ người mắc bệnh lậu

II. Phương pháp xét nghiệm bệnh lậu phổ biến
Hiện nay có rất nhiều phương pháp xét nghiệm bệnh lậu khác nhau. Cùng điểm qua những xét nghiệm được sử dụng phổ biến ngay dưới đây:
1. Xét nghiệm khuếch đại axit nucleic
Xét nghiệm khuếch đại axit nucleic giúp phát hiện DNA hoặc RNA của vi khuẩn lậu trong mẫu bệnh phẩm như nước tiểu, dịch niệu đạo, cổ tử cung, họng hoặc hậu môn. Phương pháp này sở hữu những ưu, nhược điểm như:
- Ưu điểm: Có thể xác định chính xác sự hiện diện của vi khuẩn, ngay cả khi số lượng rất ít, chưa có triệu chứng. Không cần nuôi cấy vi khuẩn, giúp tiết kiệm thời gian.
- Nhược điểm: Đòi hỏi thực hiện phòng xét nghiệm đạt chuẩn và thiết bị hiện đại
2. Xét nghiệm nuôi cấy lậu cầu
Xét nghiệm nuôi cấy lậu cầu khuẩn là phương pháp chẩn đoán được sử dụng phổ biến. Các mẫu bệnh phẩm như dịch niệu đạo, cổ tử cung, họng hoặc hậu môn được nuôi trong môi trường đặc biệt để theo dõi sự phát triển của vi khuẩn. Loại xét nghiệm này có những đặc điểm sau:
- Ưu điểm: Xét nghiệm nuôi cấy lậu cầu khuẩn có độ chính xác cao. Đồng thời, giúp bác sĩ kiểm tra mức độ kháng thuốc để lựa chọn phương pháp điều trị phù hợp.
- Nhược điểm: Thời gian trả kết quả lâu, quy trình lấy và bảo quản mẫu bệnh phẩm cũng đòi hỏi sự nghiêm ngặt.
3. Xét nghiệm nhuộm gram
Xét nghiệm nhuộm Gram thường được áp dụng để sàng lọc, hỗ trợ chẩn đoán bệnh lậu. Sau khi mẫu bệnh phẩm được nhuộm bằng thuốc nhuộm Gram sẽ được soi dưới kính hiển vi để tìm ra vi khuẩn lậu. Thực hiện xét nghiệm nhuộm Gram có nhiều lợi ích và hạn chế như sau:
- Lợi ích: Chi phí thực hiện xét nghiệm thấp, thời gian trả kết quả nhanh chóng.
- Hạn chế: Kết quả chẩn đoán bệnh lậu ở nữ giới có độ chính xác thấp.
4. Xét nghiệm nhanh PCR
PCR là một kỹ thuật khuếch đại gen kết hợp với phản ứng huỳnh quang giúp phát hiện DNA của vi khuẩn lậu nhanh chóng và chính xác. Xét nghiệm này thường được sử dụng trong các cơ sở y tế hiện đại, có những đặc điểm nổi bật như sau:
- Ưu điểm: Xét nghiệm phù hợp với cả nam giới và nữ giới, cho kết quả có độ chính xác cao
- Nhược điểm: Yêu cầu bác sĩ có trình độ chuyên môn, tay nghề giỏi, trang thiết bị thực hiện hiện đại.

III. Quy trình xét nghiệm bệnh lậu chuẩn y khoa
Tiến hành quy trình xét nghiệm bệnh lậu chuẩn y khoa sẽ mang lại độ chính xác cao. Sau đây là các bước xét nghiệm cơ bản mà mọi người nên tham khảo:
- Bước 1: Thăm khám và tư vấn: Bác sĩ sẽ hỏi bệnh sử, triệu chứng lâm sàng và thói quen tình dục của người bệnh để đánh giá nguy cơ nhiễm bệnh lậu.
- Bước 2: Lấy mẫu bệnh phẩm: Tùy theo giới tính và vị trí nghi ngờ nhiễm bệnh, bác sĩ sẽ chỉ định lấy mẫu bệnh phẩm như dịch niệu đạo, nước tiểu, dịch họng, dịch trực tràng, dịch cổ tử cung, âm đạo,…
- Bước 3: Thực hiện xét nghiệm: Mẫu bệnh phẩm sau khi thu thập được gửi đến phòng xét nghiệm để kiểm tra sự xuất hiện của vi khuẩn Neisseria gonorrhoeae.
- Bước 4: Trả kết quả và tư vấn điều trị: Khi có kết quả, bác sĩ sẽ giải thích chi tiết về kết quả xét nghiệm và tư vấn phác đồ điều trị phù hợp.
IV. Xét nghiệm lậu bao nhiêu tiền?
Thông thường, giá xét nghiệm lậu sẽ dao động từ 300.000 – 400.000 VNĐ phụ thuộc vào loại xét nghiệm, cơ sở y tế thực hiện. Để xác định chính xác chi phí xét nghiệm cần chuẩn bị, mọi người nên đến cơ sở y tế uy tín để được bác sĩ tư vấn cụ thể.

V. Lưu ý quan trọng khi xét nghiệm bệnh lậu
Để đảm bảo độ chính xác của kết quả, mọi người cần ghi nhớ những điều sau:
1. Trước khi thực hiện
- Không đi tiểu ít nhất 2 giờ trước khi lấy mẫu nước tiểu hoặc dịch niệu đạo
- Không quan hệ tình dục trong 24 giờ trước khi lấy mẫu bệnh phẩm để hạn chế nguy cơ làm sai lệch kết quả.
- Tránh xét nghiệm trong thời gian hành kinh
- Thông báo cho bác sĩ về triệu chứng, tiền sử bệnh lý, thuốc đang sử dụng
- Không sử dụng chất kích thích, đồ ăn chứa nhiều đường, chất béo,… trong vài ngày trước khi xét nghiệm
- Ngủ đủ giấc, bổ sung đầy đủ chất dinh dưỡng để có kết quả chẩn đoán chính xác
2. Sau khi nhận kết quả
- Dương tính: Điều trị đúng phác đồ và thông báo cho bạn tình cùng đi xét nghiệm, điều trị để tránh lây nhiễm qua lại.
- Âm tính: xét nghiệm lại sau 7 – 10 ngày để loại trừ giai đoạn ủ bệnh.

Tóm lại, xét nghiệm bệnh lậu đóng vai trò thiết yếu trong việc chẩn đoán chính xác và kịp thời, mở ra lộ trình điều trị hiệu quả. Mọi người nên chủ động thực hiện xét nghiệm ngay khi có nghi ngờ để bảo vệ sức khỏe cá nhân và cộng đồng. Việc này không chỉ giúp người bệnh hồi phục nhanh chóng mà còn góp phần ngăn chặn sự lây lan của bệnh.

